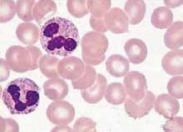

-
血清陰性脊柱關節病
628健康網為您分享有關血清陰性脊柱關節病的癥狀,血清陰性脊柱關節病的治療方法,血清陰性脊柱關節病的預防知識,血清陰性...
-
風濕性關節炎
628健康網為您分享有關風濕性關節炎的癥狀,風濕性關節炎的治療方法,風濕性關節炎的預防知識,風濕性關節炎的癥狀圖片,風...
-
多發性肌炎
628健康網為您分享有關多發性肌炎的癥狀,多發性肌炎的治療方法,多發性肌炎的預防知識,多發性肌炎的癥狀圖片,多發性肌炎...
-
自身免疫性肝病
628健康網為您分享有關自身免疫性肝病的癥狀,自身免疫性肝病的治療方法,自身免疫性肝病的預防知識,自身免疫性肝病的癥狀...
-
脂膜炎
628健康網為您分享有關脂膜炎的癥狀,脂膜炎的治療方法,脂膜炎的預防知識,脂膜炎的癥狀圖片,脂膜炎吃什么藥,脂膜炎怎么治...
-
炎癥性腸病關節炎
628健康網為您分享有關炎癥性腸病關節炎的癥狀,炎癥性腸病關節炎的治療方法,炎癥性腸病關節炎的預防知識,炎癥性腸病關節...
-
未分化脊柱關節病
628健康網為您分享有關未分化脊柱關節病的癥狀,未分化脊柱關節病的治療方法,未分化脊柱關節病的預防知識,未分化脊柱關節...
-
無肌病性皮肌炎
628健康網為您分享有關無肌病性皮肌炎的癥狀,無肌病性皮肌炎的治療方法,無肌病性皮肌炎的預防知識,無肌病性皮肌炎的癥狀...
-
白塞病
628健康網為您分享有關白塞病的癥狀,白塞病的治療方法,白塞病的預防知識,白塞病的癥狀圖片,白塞病吃什么藥,白塞病怎么治...
-
指節墊
628健康網為您分享有關指節墊的癥狀,指節墊的治療方法,指節墊的預防知識,指節墊的癥狀圖片,指節墊吃什么藥,指節墊怎么治...
-
鼻腫瘤
628健康網為您分享有關鼻腫瘤的癥狀,鼻腫瘤的治療方法,鼻腫瘤的預防知識,鼻腫瘤的癥狀圖片,鼻腫瘤吃什么藥,鼻腫瘤怎么治...
-
外耳道真菌病
628健康網為您分享有關外耳道真菌病的癥狀,外耳道真菌病的治療方法,外耳道真菌病的預防知識,外耳道真菌病的癥狀圖片,外...
-
前列腺增生
628健康網為您分享有關前列腺增生的癥狀,前列腺增生的治療方法,前列腺增生的預防知識,前列腺增生的癥狀圖片,前列腺增生...
-
自身敏感性皮炎
628健康網為您分享有關自身敏感性皮炎的癥狀,自身敏感性皮炎的治療方法,自身敏感性皮炎的預防知識,自身敏感性皮炎的癥狀...
-
老年性陰道炎
628健康網為您分享有關老年性陰道炎的癥狀,老年性陰道炎的治療方法,老年性陰道炎的預防知識,老年性陰道炎的癥狀圖片,老...
-
多形紅斑
628健康網為您分享有關多形紅斑的癥狀,多形紅斑的治療方法,多形紅斑的預防知識,多形紅斑的癥狀圖片,多形紅斑吃什么藥,多...
-
鼻血管瘤
628健康網為您分享有關鼻血管瘤的癥狀,鼻血管瘤的治療方法,鼻血管瘤的預防知識,鼻血管瘤的癥狀圖片,鼻血管瘤吃什么藥,鼻...
-
妊娠合并糖尿病
628健康網為您分享有關妊娠合并糖尿病的癥狀,妊娠合并糖尿病的治療方法,妊娠合并糖尿病的預防知識,妊娠合并糖尿病的癥狀...
-
脈管炎
628健康網為您分享有關脈管炎的癥狀,脈管炎的治療方法,脈管炎的預防知識,脈管炎的癥狀圖片,脈管炎吃什么藥,脈管炎怎么治...
-
肝病
628健康網為您分享有關肝病的癥狀,肝病的治療方法,肝病的預防知識,肝病的癥狀圖片,肝病吃什么藥,肝病怎么治療,肝病患者食...
-
腸阿米巴病
628健康網為您分享有關腸阿米巴病的癥狀,腸阿米巴病的治療方法,腸阿米巴病的預防知識,腸阿米巴病的癥狀圖片,腸阿米巴病...
-
妊娠合并肝炎
628健康網為您分享有關妊娠合并肝炎的癥狀,妊娠合并肝炎的治療方法,妊娠合并肝炎的預防知識,妊娠合并肝炎的癥狀圖片,妊...
-
蠕蟲病
628健康網為您分享有關蠕蟲病的癥狀,蠕蟲病的治療方法,蠕蟲病的預防知識,蠕蟲病的癥狀圖片,蠕蟲病吃什么藥,蠕蟲病怎么治...
-
骨髓炎
628健康網為您分享有關骨髓炎的癥狀,骨髓炎的治療方法,骨髓炎的預防知識,骨髓炎的癥狀圖片,骨髓炎吃什么藥,骨髓炎怎么治...
-
隱球菌病
628健康網為您分享有關隱球菌病的癥狀,隱球菌病的治療方法,隱球菌病的預防知識,隱球菌病的癥狀圖片,隱球菌病吃什么藥,隱...
-
葡萄球菌感染
628健康網為您分享有關葡萄球菌感染的癥狀,葡萄球菌感染的治療方法,葡萄球菌感染的預防知識,葡萄球菌感染的癥狀圖片,葡...
-
流注
628健康網為您分享有關流注的癥狀,流注的治療方法,流注的預防知識,流注的癥狀圖片,流注吃什么藥,流注怎么治療,流注患者食...
-
鼠咬傷
628健康網為您分享有關鼠咬傷的癥狀,鼠咬傷的治療方法,鼠咬傷的預防知識,鼠咬傷的癥狀圖片,鼠咬傷吃什么藥,鼠咬傷怎么治...
-
楊梅瘡
628健康網為您分享有關楊梅瘡的癥狀,楊梅瘡的治療方法,楊梅瘡的預防知識,楊梅瘡的癥狀圖片,楊梅瘡吃什么藥,楊梅瘡怎么治...
-
肝功能衰竭
628健康網為您分享有關肝功能衰竭的癥狀,肝功能衰竭的治療方法,肝功能衰竭的預防知識,肝功能衰竭的癥狀圖片,肝功能衰竭...
-
老年癌癥病人的急性感染
628健康網為您分享有關老年癌癥病人的急性感染的癥狀,老年癌癥病人的急性感染的治療方法,老年癌癥病人的急性感染的預防...
-
小兒肺隔離癥
628健康網為您分享有關小兒肺隔離癥的癥狀,小兒肺隔離癥的治療方法,小兒肺隔離癥的預防知識,小兒肺隔離癥的癥狀圖片,小...
-
中性粒細胞減少癥
628健康網為您分享有關中性粒細胞減少癥的癥狀,中性粒細胞減少癥的治療方法,中性粒細胞減少癥的預防知識,中性粒細胞減少...
-
中性白(粒)細胞減少癥
628健康網為您分享有關中性白(粒)細胞減少癥的癥狀,中性白(粒)細胞減少癥的治療方法,中性白(粒)細胞減少癥的預防知識,中性...
-
新生兒溶血癥
628健康網為您分享有關新生兒溶血癥的癥狀,新生兒溶血癥的治療方法,新生兒溶血癥的預防知識,新生兒溶血癥的癥狀圖片,新...
-
椎間隙感染
628健康網為您分享有關椎間隙感染的癥狀,椎間隙感染的治療方法,椎間隙感染的預防知識,椎間隙感染的癥狀圖片,椎間隙感染...
-
自身紅細胞過敏性紫癜
628健康網為您分享有關自身紅細胞過敏性紫癜的癥狀,自身紅細胞過敏性紫癜的治療方法,自身紅細胞過敏性紫癜的預防知識...
-
中性粒細胞增多癥
628健康網為您分享有關中性粒細胞增多癥的癥狀,中性粒細胞增多癥的治療方法,中性粒細胞增多癥的預防知識,中性粒細胞增多...
-
貧血伴發的精神障礙
628健康網為您分享有關貧血伴發的精神障礙的癥狀,貧血伴發的精神障礙的治療方法,貧血伴發的精神障礙的預防知識,貧血伴發...
-
嗜酸性粒細胞增多癥
628健康網為您分享有關嗜酸性粒細胞增多癥的癥狀,嗜酸性粒細胞增多癥的治療方法,嗜酸性粒細胞增多癥的預防知識,嗜酸性粒...
-
風濕病
628健康網為您分享有關風濕病的癥狀,風濕病的治療方法,風濕病的預防知識,風濕病的癥狀圖片,風濕病吃什么藥,風濕病怎么治...
-
脾亢
628健康網為您分享有關脾亢的癥狀,脾亢的治療方法,脾亢的預防知識,脾亢的癥狀圖片,脾亢吃什么藥,脾亢怎么治療,脾亢患者食...
-
組織細胞壞死性淋巴結炎
628健康網為您分享有關組織細胞壞死性淋巴結炎的癥狀,組織細胞壞死性淋巴結炎的治療方法,組織細胞壞死性淋巴結炎的預防...
-
噬血細胞綜合癥
628健康網為您分享有關噬血細胞綜合癥的癥狀,噬血細胞綜合癥的治療方法,噬血細胞綜合癥的預防知識,噬血細胞綜合癥的癥狀...
-
腦栓塞
628健康網為您分享有關腦栓塞的癥狀,腦栓塞的治療方法,腦栓塞的預防知識,腦栓塞的癥狀圖片,腦栓塞吃什么藥,腦栓塞怎么治...
-
黑熱病
628健康網為您分享有關黑熱病的癥狀,黑熱病的治療方法,黑熱病的預防知識,黑熱病的癥狀圖片,黑熱病吃什么藥,黑熱病怎么治...
-
小兒過敏性紫癜
628健康網為您分享有關小兒過敏性紫癜的癥狀,小兒過敏性紫癜的治療方法,小兒過敏性紫癜的預防知識,小兒過敏性紫癜的癥狀...
-
組織細胞增殖癥
628健康網為您分享有關組織細胞增殖癥的癥狀,組織細胞增殖癥的治療方法,組織細胞增殖癥的預防知識,組織細胞增殖癥的癥狀...
-
慢性血源性骨髓炎
628健康網為您分享有關慢性血源性骨髓炎的癥狀,慢性血源性骨髓炎的治療方法,慢性血源性骨髓炎的預防知識,慢性血源性骨髓...
-
冷球蛋白血癥
628健康網為您分享有關冷球蛋白血癥的癥狀,冷球蛋白血癥的治療方法,冷球蛋白血癥的預防知識,冷球蛋白血癥的癥狀圖片,冷...